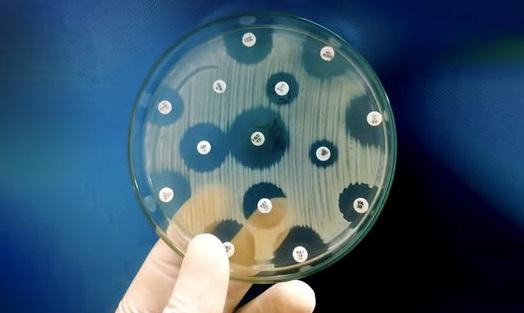

Сайт bigkyiv.com.ua призначений для осіб які старші 21 року (21+). Участь в азартних іграх може викликати ігрову залежність. Дотримуйтесь правил (принципів) відповідальної гри.
© 2015 - 0000 ТОВ "Інформаційне агентство "Великий Київ". Всі права захищені
ВЩ
ВЩ